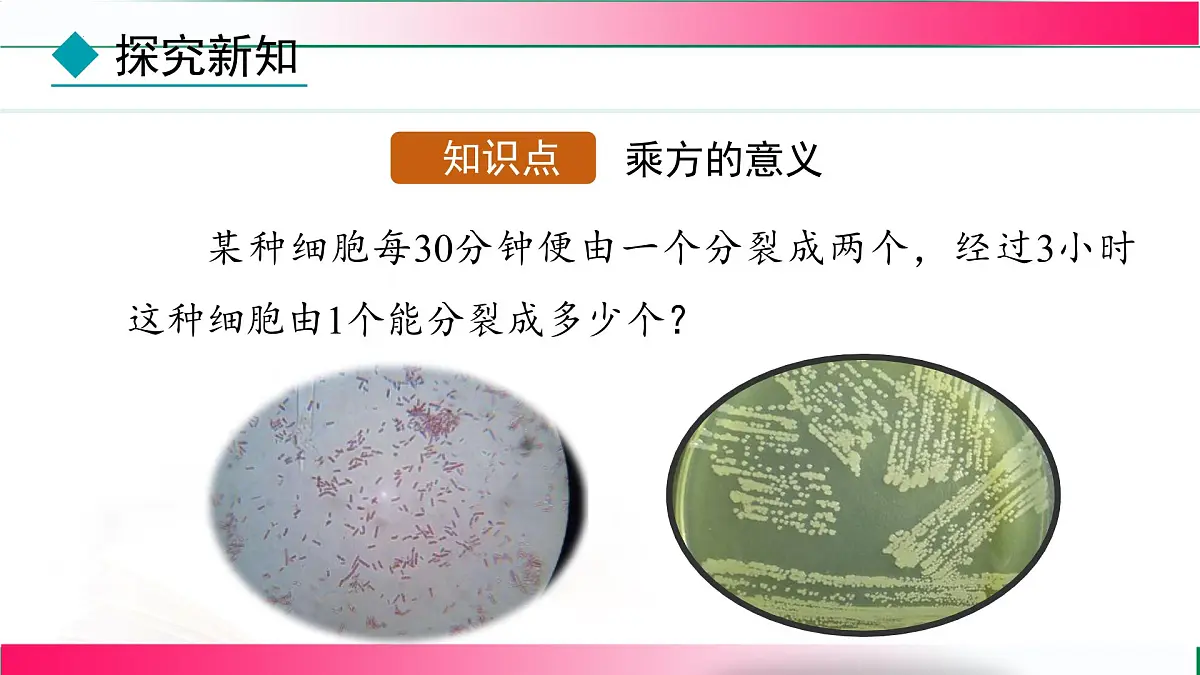
2.3.1 乘方 （第1课时） 课件2024-2025学年人教版七年级数学上册第5页

所属成套资源:七年级数学上册同步教学课件(人教版2024)
七年级上册(2024)有理数的乘方教课内容课件ppt
展开 这是一份七年级上册(2024)有理数的乘方教课内容课件ppt,共36页。PPT课件主要包含了乘方的意义,分裂方式如下所示,分裂两次呢,分裂三次呢四次呢,×2个,×2×2个,×2×2×2个,例如2×2×2×2,试一试,例1计算等内容,欢迎下载使用。
理解并掌握有理数的乘方、幂、底数、指数的概念及意义.体会有理数乘方运算的符号法则,熟练进行有理数的乘方运算.
珠穆朗玛峰是世界最高的山峰,它的海拔高度约是8848.86米.把一张足够大的厚度为0.1毫米的纸,连续对折30次的厚度能超过珠穆朗玛峰,这是真的吗?
某种细胞每30分钟便由一个分裂成两个,经过3小时这种细胞由1个能分裂成多少个?
这个细胞分裂一次可得多少个细胞?
那么,3小时共分裂了多少次?有多少个细胞?
解: 一次: 两次: 三次: 四次:
六次: 2×2×2×2×2×2个.
请比较细胞分裂四次后的个数式子:2×2×2×2和细胞分裂六次后的个数式子: 2×2×2×2×2×2. 这两个式子有什么相同点?
它们都是乘法,并且它们各自的因数都相同.
【想一想】这样的运算能像平方、立方那样简写吗?
一般地,n个相同的因数a相乘,记作an,读作“a的n次幂(或a的n次方)”,即
2×2×2×2×2×2
读作2的6次方(幂).
读作2的4次方(幂).
这种求n个相同因数的积的运算叫做乘方,乘方的结果叫做幂.
一个数可以看作这个数本身的一次方,例如,8就是81,指数1通常省略不写. 因为an就是n个a相乘,所以可以利用有理数的乘法运算来进行有理数的乘方运算.
1. (–5)2的底数是_____,指数是_____,(–5)2表示2个_____相乘,读作_____的2次方,也读作–5的_____.
2. 表示 个 相乘,读作 的 次方,也读作 的 次幂,其中 叫做 ,6叫做 .
温馨提示:幂的底数是分数或负数时,底数应该添上括号!
解:(1)(–4)3=(–4)×(–4)×(–4)=–64;
(2)(–2)4 =(–2)×(–2)×(–2)×(–2)=16;
你发现负数的幂的正负有什么规律?
1.负数的奇次幂是负数,负数的偶次幂是正数.
2.正数的任何正整数次幂都是正数,0的任何正整数次幂都是0.
根据有理数的乘法法则可以得出:
判断:(对的画“√”,错的画“×”.)
(1) 32 = 3×2 = 6;( )
(2)(–2)3 = (–3)2; ( )
(3) –32 = (–3)2;( )
32 = 3×3=9
(–2)3=–8;(–3)2=9
–32 = –9; (–3)2=9
(4) ;( )
(5) . ( )
–24= –2×2×2×2= –16
例2 用计算器计算(–8)5和(–3)6.
利用计算器进行乘方的计算
所以(–8)5= –32768,(–3)6=729.
(1) =_________
(2) =___________
(3) =_________
(4) =__________
若运用初中数学教材中使用的某种电子计算器进行计算,则按键的结果为( )A.16 B.33 C.37 D.36
(1) (2)–23×(–32) (3)64÷(–2)5 (4)(–4)3÷(–1)200+2×(–3)4
(2) –23×(–32)= –8×(–9)=72;
(3)64÷(–2)5=64÷(–32)= –2;
(4)(–4)3÷(–1)200+2×(–3)4 = –64÷1+2×81=98
【思考】通过以上计算,对于乘除和乘方的混合运算, 你觉得有怎样的运算顺序?
先算乘方,后算乘除;如果遇到括号,就先进行括号里的运算.
解:(1)原式= = 1
(2)原式= = 4
(3)原式=–2×3–36= –42
2. [2023·杭州](-2)2+22=( D )
3. -36表示的意义是( B )
3和6相乘的相反数是-3×6;6个3相乘的相反数是-36;3个-6相乘是(-6)3;3个6相乘的相反数是-63.
4. [母题·教材P52练习T1 2024·湘潭雨湖区期末]下列说法正确的是( C )
5. 与下面科学计算器的按键顺序:
0 · 6 × 5 ab/c 6 + 1 2 ∧ 4 对应的计算任务是( B )
6. [2024·德州乐陵市期末]下列各组数中,运算结果相等的是( A )
7. [新考向 数学文化]13世纪数学家斐波那契的《计算书》中有这样一个问题:“在罗马有7位老妇人,每人赶着7头毛驴,每头毛驴驮着7只口袋,每只口袋里装着7个面包,每个面包附有7把餐刀,每把餐刀有7只刀鞘,”则刀鞘数为( C )
根据题意,得刀鞘数为7×7×7×7×7×7=76.
1.求几个相同因数的积的运算,叫做乘方.
(1)正数的任何次幂都是正数.
(2)负数的奇次幂是负数,负数的偶次幂是正数.
(3)零的正整数次幂都是零.
相关课件
这是一份七年级上册(2024)有理数的乘方教课内容课件ppt,共36页。PPT课件主要包含了乘方的意义,分裂方式如下所示,分裂两次呢,分裂三次呢四次呢,×2个,×2×2个,×2×2×2个,例如2×2×2×2,试一试,例1计算等内容,欢迎下载使用。
这是一份初中数学人教版(2024)七年级上册(2024)2.3 有理数的乘方课前预习ppt课件,共21页。PPT课件主要包含了复习巩固,讲授新课,要求真的不多吗,a的n次方,想通因数的个数,精讲例题,与32,探究2,巩固练习,拓展提高等内容,欢迎下载使用。
这是一份人教版(2024)七年级上册2.3 有理数的乘方图文课件ppt,文件包含第1课时有理数的乘方pptx、有理数的乘方mp4等2份课件配套教学资源,其中PPT共23页, 欢迎下载使用。
相关课件 更多
- 1.电子资料成功下载后不支持退换,如发现资料有内容错误问题请联系客服,如若属实,我们会补偿您的损失
- 2.压缩包下载后请先用软件解压,再使用对应软件打开;软件版本较低时请及时更新
- 3.资料下载成功后可在60天以内免费重复下载
 免费领取教师福利
免费领取教师福利 






.png)




